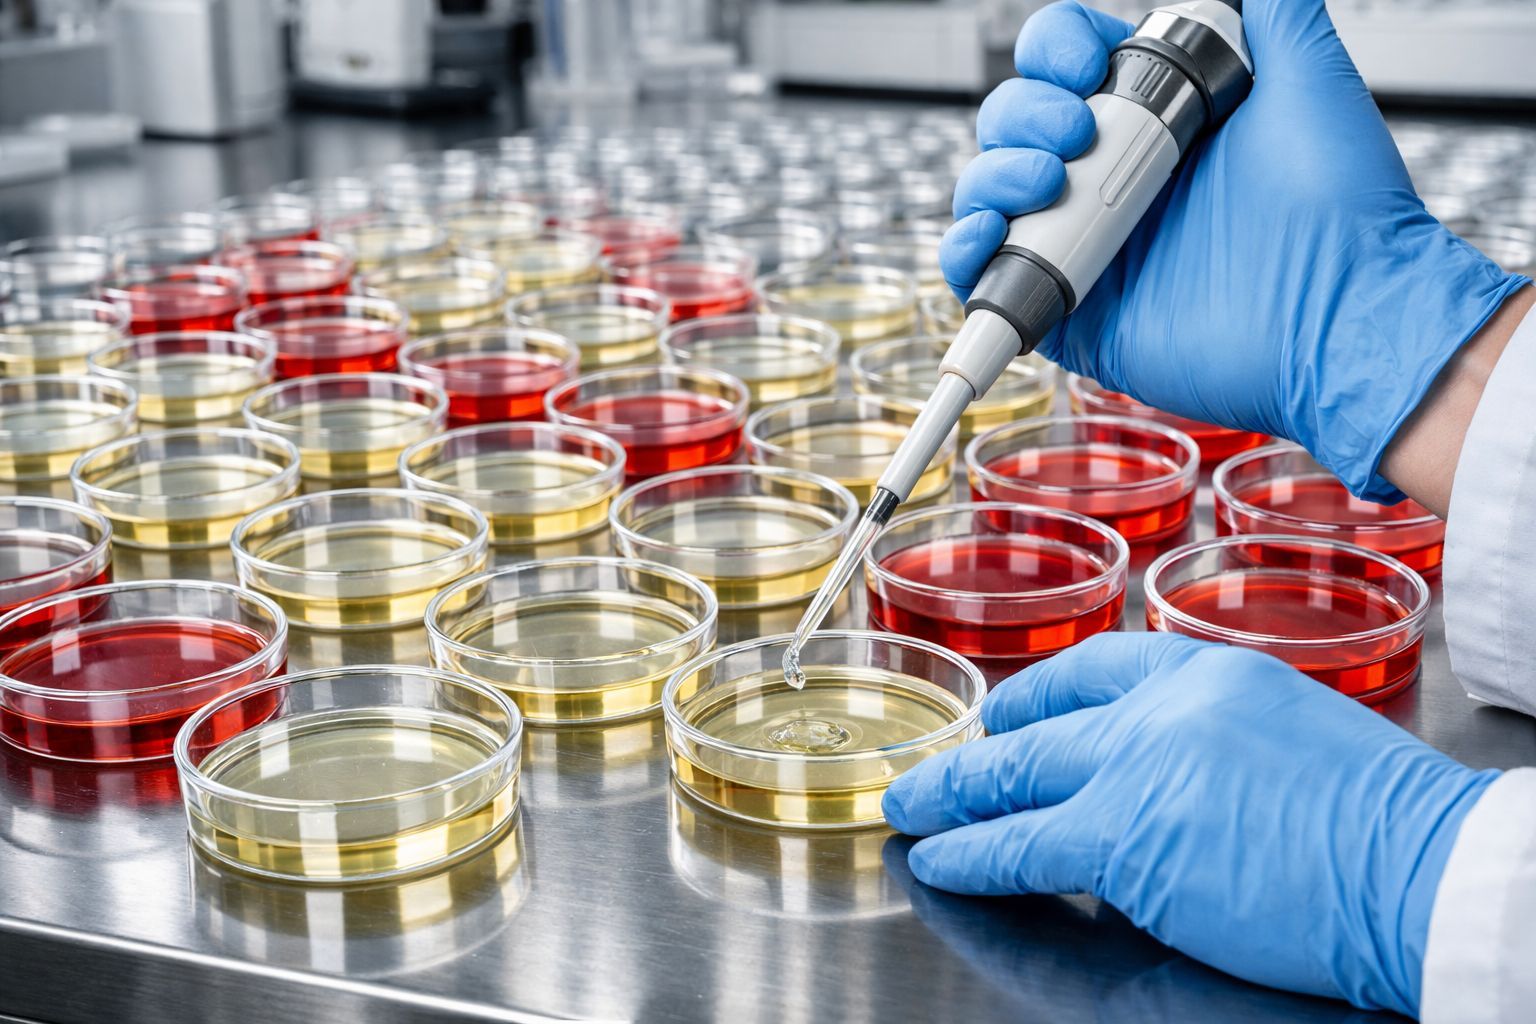

Parkinson : Des chercheurs identifient enfin les « passeurs » responsables de la propagation de la maladie
Auteur: Mathieu Gagnon
Une percée majeure venue de Yale

C’est une nouvelle qui redonne, je pense, une bonne dose d’espoir. Selon des recherches récentes menées par la Yale School of Medicine (YSM), deux protéines situées à la surface des motoneurones pourraient jouer un rôle absolument central dans la progression de la maladie de Parkinson. L’information nous vient d’un article de Freda Kreier, édité par Lisa Lock et révisé par Robert Egan, qui met en lumière cette découverte fascinante publiée dans la revue Nature Communications. Vous savez, la maladie de Parkinson est cette affection neurodégénérative terrible où les neurones du cerveau se dégradent lentement et finissent par mourir. On savait déjà que cette mort cellulaire est causée par l’accumulation d’une protéine mal repliée, l’α-synucléine (ou alpha-synucléine), qui se propage d’un neurone à l’autre comme une mauvaise herbe. Mais voilà, le mécanisme exact, la façon dont cette « mauvaise » protéine passait d’une cellule à l’autre, restait un mystère total… jusqu’à maintenant.
L’étude suggère que deux protéines membranaires spécifiques — appelées mGluR4 et NPDC1 — sont les acteurs principaux de ce transport indésirable. Ce sont elles qui feraient entrer l’α-synucléine mal repliée dans les neurones sains après qu’elle se soit échappée des neurones mourants. Le Dr Stephen Strittmatter, auteur principal de l’étude, professeur de neurologie (chaire Vincent Coates) et président du département de neurosciences à l’YSM, est assez clair là-dessus. Il explique que cette protéine mal repliée est la « marque pathologique de la maladie de Parkinson ». Sa réflexion est logique : si nous comprenons comment elle pénètre dans les neurones, nous pourrions peut-être bloquer ou ralentir la maladie. Mais pour en arriver là, il fallait impérativement comprendre le mécanisme moléculaire de cette propagation. C’est un peu comme trouver la clé avant de pouvoir verrouiller la porte.
La traque des protéines : une enquête à grande échelle
Il faut se rendre compte de l’ampleur du problème. Les maladies neurodégénératives comme Alzheimer et Parkinson sont devenues une préoccupation sanitaire majeure, surtout ici, aux États-Unis. La Parkinson’s Foundation estime qu’environ 1,1 million d’Américains ont reçu un diagnostic de Parkinson, et ce qui est effrayant, c’est que près de 90 000 personnes supplémentaires rejoignent leurs rangs chaque année. Les gens touchés connaissent bien les symptômes : tremblements, problèmes d’équilibre, mouvements ralentis… Tout cela est dû à cette fameuse accumulation d’α-synucléine mal repliée dans les cellules motrices. Et plus elle se propage, plus les symptômes s’aggravent. C’est un cercle vicieux.
Pour comprendre comment cette protéine entrait dans les nouvelles cellules, Strittmatter et ses collègues ont supposé qu’elle devait se lier à des protéines de surface. Ils n’ont pas fait les choses à moitié : ils ont créé pas moins de 4 400 lots de cellules ! Chacun exprimait des protéines de surface différentes. Imaginez le travail de fourmi pour observer si elles se liaient à l’α-synucléine mal repliée. La plupart ne l’ont pas fait, heureusement. Mais 16 d’entre elles l’ont fait. Parmi ces finalistes, les chercheurs ont identifié deux protéines présentes dans les neurones dopaminergiques humains de la substance noire (substantia nigra), cette région du cerveau qui dégénère justement dans la maladie de Parkinson. Ces deux coupables, mGluR4 et NPDC1, transportaient bel et bien la protéine toxique à l’intérieur de la cellule.
Vers de nouveaux traitements : l’espoir confirmé par les souris

Ces résultats ont mis la puce à l’oreille de l’équipe : ces protéines de surface pouvaient être les « passeurs ». Pour tester cette théorie, ils ont génétiquement modifié des souris pour qu’elles aient des copies non fonctionnelles de mGluR4 ou de NPDC1, puis ils ont introduit l’α-synucléine mal repliée. Le résultat est assez bluffant. Chez les souris « normales », la protéine toxique s’est accumulée et elles ont développé des symptômes semblables à ceux de Parkinson. Par contre, chez les souris dépourvues de mGluR4 ou NPDC1 fonctionnels… rien, ou presque. Les neurones dopaminergiques étaient préservés. Les chercheurs ont aussi découvert qu’en éliminant les gènes de ces deux protéines dans un modèle de souris atteint de Parkinson, cela réduisait le risque de mort et la progression des symptômes. En gros, mGluR4 et NPDC1 travaillent ensemble pour propager la maladie.
Stephen Strittmatter souligne que ces découvertes offrent une voie potentielle pour traiter la maladie, enfin ! Les interventions actuelles se concentrent surtout sur la réduction des symptômes, mais elles n’empêchent pas la maladie d’avancer. En s’attaquant directement à la propagation de l’α-synucléine, on pourrait ralentir, voire arrêter le cours de la maladie. C’est crucial, surtout quand on pense à l’avenir. Parkinson frappe surtout les personnes âgées, et le nombre d’Américains de plus de 65 ans va exploser dans les prochaines décennies. « Nous avons une population vieillissante. Comment empêcher ou ralentir la mort des neurones est un problème énorme », insiste Strittmatter. Il a raison, c’est vraiment le moment de faire des progrès pour comprendre comment freiner tout ça.
Selon la source : medicalxpress.com
Ce contenu a été créé avec l’aide de l’IA.